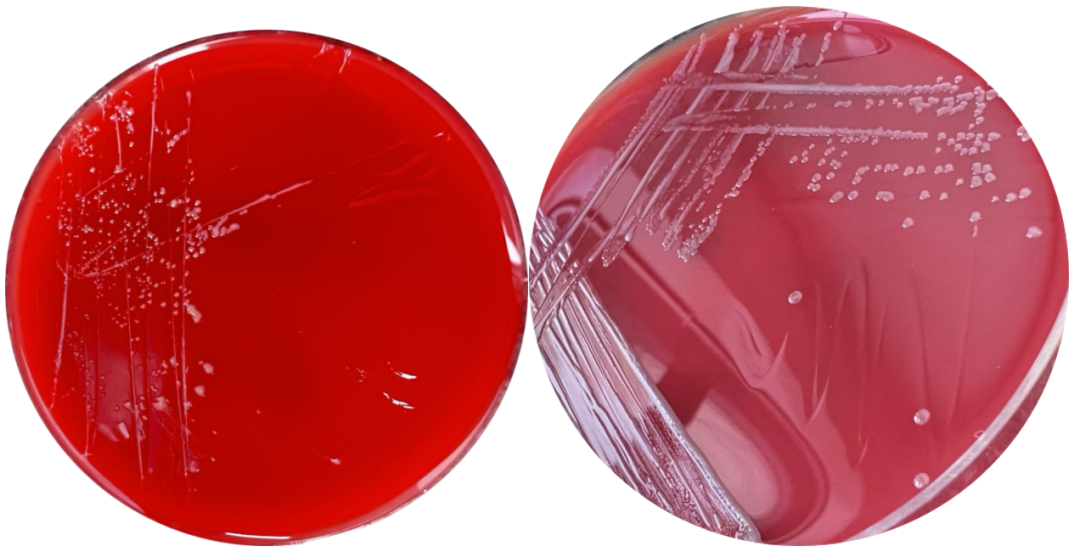

2023-08-17 17:20
作者 姚莉、成莉

京港感染论坛
多学科合作,构建诊断管理体系
弯曲菌是一种食源性人畜共患病原菌,是腹泻的常见病因之一,其中空肠弯曲菌是导致人类弯曲菌病的重要菌种,当感染严重时病原菌可侵入血液,引起全身感染症状。回顾我院空肠弯曲菌引起血流感染一例,该病例的诊疗过程并不复杂,但由于弯曲菌对体外培养要求十分苛刻,培养时间较长,同时弯曲菌在血培养阳性标本涂片中,呈革兰染色阴性,染色浅且菌体细小,使其实验室诊断具有一定的挑战性,对微生物检验工作者的经验水平要求较高,极易出现漏检。通过该病例,分享几点经验和体会。
![]()
▼ 一、病情摘要
患儿,男,1岁9月龄。入院前1-天,无明显诱因出现发热、腹痛,以高热为主,热峰39.8C,无寒战、抽搐,伴少许流涕、喷囔;腹痛较剧烈,脐周为主,无牵涉痛及放射痛,伴腹胀,伴呕吐1次,非喷射性,呕吐物为胃内容物,不含胆汁及咖啡样物质,解黄色稀便1次,无黏液及脓血,无烦躁不安,无嗜睡、昏迷,无气促、发绀,无皮疹、紫癜。
在县医院以"喜炎平、补液"对症治疗后,患儿发热、腹痛无缓解,患者为进一步治疗来我院就诊,以“全身炎症反应综合征”于2023年2月22日收治入院。
▼ 二、辅助检查
2023年2月21日(县医院):WBC 6.6x10^9/L,中性粒百分比42.3%,淋巴细胞百分比45.4%,超敏C反应蛋白92.19mg/L,PCT 12.38ng/mL。
2023年2月22日:在我院门诊行急腹症超声检查考虑肠套叠。
2023年2月22日:WBC 6.44x10^9/L,中性粒百分比58.3%,淋巴细胞百分比25.0%,超敏C反应蛋白152.36mg/L。大便隐血阳性,轮状病毒抗原阴性。
2023年2月23日复查腹部超声显示,未见明确急腹症征象。
▼ 三、微生物学检查
2023年2月22日送检血培养,2.78天报阳,常规转钟并涂片革兰染色后镜检。在首次涂片时镜下未查见明确细菌形态,查看血培养瓶生长曲线发现有轻微上升趋势(见图1),于是进行第二次涂片,同时进行革兰染色和瑞氏染色。在瑞氏染色的图片中发现细长弯曲的菌体(见图2),有目的性地观察革兰染色涂片,发现许多细小的弯曲杆菌(见图3),后报告危急值。

▲图1 血培瓶生长曲线

▲图2 血培养阳性培养物瑞氏染色

▲图3 血培养阳性培养物革兰染色
阳性血培养液转至血平板,在5%CO2,35℃环境中孵育24小时后可查见湿润的细小菌落(见图4),孵育48小时后可见湿润、灰白色菌落(见图5),挑取少许菌落涂片,革兰染色后镜检如图6所示,采用MALDI-TOF鉴定为空肠弯曲菌,鉴定分数>9,结果可信。
▲图4 5% CO235℃环境孵育培养24小时菌落
▲图5 5% CO235℃环境孵育培养48小时菌落

▲图6 空肠弯曲菌纯菌落涂片
▼ 四、诊治经过
入院后予以哌拉西林他唑巴坦抗感染治疗,西咪替丁护胃,维生素B6止吐,补钾等对症治疗,患儿症状明显缓解,未再次出现发热、呕吐等症状,家属要求出院,医生考虑到患儿感染指标高,且疗程尚短,建议继续住院治疗,但家属仍然坚持,于2023年2月24日签字出院。血培养结果出具后,通过电话沟通,患儿恢复情况良好。
因我院条件有限,无法进行空肠弯曲菌的药敏试验。根据CLSI M45(2015年),空肠弯曲菌的抗菌药物选择和药敏试验结果判断折点见表1,纸片扩散法采用含5%羊血MH琼脂,微量肉汤法采用阳离子调节MH肉汤,并补充2.5~5%裂解马血,在微需氧环境(10%CO2,5%O2,85%N2),42℃孵育24h,微量肉汤稀释法还可采用36~37℃环境下孵育48h。红霉素药敏结果可预测阿奇霉素的敏感性。
表1 空肠弯曲菌药敏试验结果判断折点

《ABX指南》中指出,空肠弯曲菌引起的胃肠炎最根本的治疗手段是补液,多数患者不需要使用抗生素。治疗首选红霉素,也可用阿奇霉素代替红霉素,但对阿奇霉素的研究没红霉素充分,次选环丙沙星。静脉用药时可选用氨基糖苷类、氯霉素、克林霉素和卡巴培南类药物。
该病例入院后采用经验性用药,同时给予补液对症治疗,患儿明显缓解。虽没有使用指南推荐的抗菌药物进行治疗,但由于空肠弯曲菌感染具有自限性,哌拉西林他唑巴坦可能具有一定的抗菌作用,且同时采用了补液等对症治疗,因此患儿得以较快好转。
▼ 五、经验与体会
弯曲菌属是一群菌体呈弧形、S形、逗点状、螺旋形的革兰染色阴性杆菌,微需氧,生长温度35~42℃,在25℃不生长。初次培养时,在5%O2,10%CO2,85%N2的环境中可提高检出率。弯曲菌属是引起细菌性腹泻的最常原因之一,其中近90%的弯曲菌感染病例是由空肠弯曲菌引起。通常表现为以腹泻为主的急性肠炎,也可出现肠外感染,如菌血症、脓肿、脑膜炎等。在大多数病例中,弯曲菌感染为自限性疾病,但在幼儿、老人、免疫力低下的人群中可引起肠外感染和感染并发症[1,2]。
有报道[3]称空肠弯曲菌感染与格林-巴利综合症密切相关。2007年我国吉林长春市有36人因感染空肠弯曲菌而出现格林-巴利综合征的爆发,且国外也常有弯曲菌感染导致格林-巴利综合征爆发的报道,因此,空肠弯曲菌的感染不容小觑。
在日常工作中,当血培养系统产生阳性信号,但涂片未见任何微生物生长,传代后未出现微生物生长时,该病例认为是假阳性。常见原因主要有抽血量太多,白细胞过多等。虽然日常工作中血培养仪报假阳性情况时有发生,但我们仍然不可松懈。在排除仪器、环境、抽血等影响因素外,我们还应该做好以下几个方面,避免漏检。
第一、观察血培养的生长曲线,若曲线平缓,假阳性可能性大,若曲线已出现上升趋势,则需要提高警惕。第二、查看血培养瓶底部颜色及抽血量。真阳性瓶以及空瓶的颜色进行对比,真阳性瓶底部颜色通常会明显加深。因血细胞本身也会发酵产生CO2,因此当抽血量超过推荐采血量时也会导致假阳性的发生。第三、查看患者病历及相关辅助检查,在白血病、真性红细胞增多症等疾病时,细胞大量增加时也会导致假阳性。另外结合患者病史、感染指标等综合判断。第四、换不同的工作人员观察涂片,微生物工作者的经验水平和敏锐性各有不同,多人查看可提高检出率。由于血培养阳性时多以肠杆菌科、葡萄球菌属和链球菌属多见,作为微生物工作人员不可过于主观,要对一些少见菌种保持警惕心,例如布鲁菌、弯曲菌等。第五、若仍未观察到明确的菌体,可充分混匀血培养瓶重新涂片,同时进行革兰染色和瑞氏染色。革兰染色的背景整体呈红色,加之存在大量红细胞,细小的革兰阴性菌较易漏检。而瑞士染色可将红细胞和细菌菌体区分开,更易查见细菌菌体,降低漏检率。
参考资料(上下滑动)
[1] 黄颖凤,张弛,周显元,等. 一例儿童空肠弯曲菌血培养阳性的病例报道[J]. 医学检验 与临床,2022,33(6):82-84.
[2] Fitzgerald C. Campylobacter. Clin Lab Med. 2015 Jun;35(2):289-298.
[3] 张茂俊,顾一心,李颖,等. 空肠弯曲菌、结肠弯曲菌检验方法团体标准解读[J]. 中华流行病学杂志,2019,40(9):1052-1054.
▲点击图片,关注2023京港年会

姚莉
主管检验技师,医学硕士,就职于乐山市人民医院检验科,主要从事临床微生物工作,2020年9月到2021年2月在华西医院进修,参与国家青年课题1项,具有较丰富的临床经验。

成莉
就职于乐山市人民医院,主管检验技师,主要从事临床微生物检验工作。2021年6月至2021年12月在解放军总医院第一医学中心进修,参与国家青年课题1项,具有较丰富的临床经验。
END
作者|姚莉、成莉(乐山市人民医院)
审校|王占伟(北京大学人民医院)

